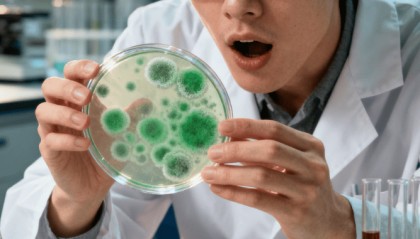
青霉素的发现：弗莱明实验室最值钱的 “邋遢”

-

恒大「最值钱」的资产终于要卖了
作者|王晗玉 编辑| 张 帆 封面来源|视觉中国 继“卖身”合生创展只差临门一脚却无奈终止之后,恒...
芝麻开门交易所 2025-10-09 21
-

12星座谁最单纯,12星座谁的眼泪最值钱
在浩瀚的星空下,12星座各自闪耀着独特的光芒。他们或深沉、或热烈、或神秘,但在这璀璨的星河中,总有那...
Gate.io交易平台 2025-10-09 18
-

懂得经营分析的财务BP,最值钱
当业务团队拿着实时数据看板追问增长策略,当管理层需要从报表中预见市场风险,传统财务的核算职能正面临前...
Gate.io交易平台 2025-10-09 17
-

下半年,最值钱的一段话!
下半年,最值钱的一段话, 送给所有的朋友们: 不要炫耀你的钱有多少, 不要炫耀你的房有多大, 不要炫...
Gate.io交易平台 2025-10-09 16
-

2025最难考也是最值钱的十大职业证书推荐
最近收到很多职场人咨询:"哪些证书既难考又含金量高?"我连夜整理了这份2025最新证书榜单,帮你划出...
Gate.io交易所 2025-10-09 21
-

人这一辈子,什么最值钱?
人生就像一场奇妙的旅程,在这漫长的道路上,我们不断地追寻着各种东西,金钱、名誉、地位……然而,人这一...
Gate.io交易平台 2025-10-09 20
-

辽宁哪个品牌最值钱,最新榜单出炉!
来源:滚动播报 (来源:东北新闻网) 为引导企业和区域增强品牌意识,推进我省品牌建设,提升企业和区域...
芝麻开门交易所 2025-10-09 17
-

最难考也是最值钱的十大证书
想要在职场中脱颖而出,一本含金量高且行业广泛认可的专业证书,能让你如虎添翼!但哪些证书真正值得挑战?...
芝麻开门交易所 2025-10-09 15
-

青霉素的发现:弗莱明实验室最值钱的 “邋遢”
1928 年秋,亚历山大・弗莱明推开实验室门时,估计自己都皱了眉。俩礼拜前赶著去海滨度假,实验台压...
Gate.io交易平台 2025-10-09 17
-

数学专业考哪些证书最值钱
数学专业考哪些证书最值钱?2025年这8本证书闭眼入 🚀 数学作为“万理之基”,在不同领域都能成为职...
芝麻开门交易所 2025-10-09 15